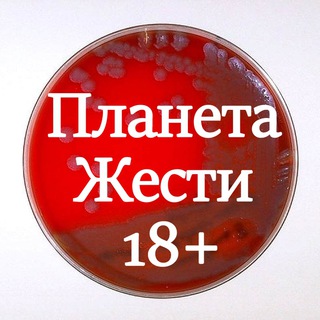

Планета жести 18+
180 subscribers
Много разной видеожести со всех уголков планеты: аварии, происшествия, стихийные бедствия, драки, случайные смерти и многое другое.
По всем вопросам обращаться: @lakusha_5, @mercuso4
По всем вопросам обращаться: @lakusha_5, @mercuso4
If you have Telegram, you can view and join
Планета жести 18+ right away.
Планета жести 18+ right away.